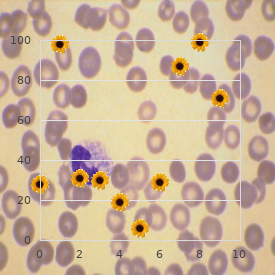

Purchase Prilosec with paypal
New College of Florida. J. Dargoth, MD: "Purchase Prilosec with paypal".
Undeveloped outcome materials (attrition predisposition) Insufficient chance Of the 61 original participants discount 40 mg prilosec free shipping gastritis diet 17, 10 partici- All outcomes - drop-outs? High-pitched risk No discussion or controlling for the benefit of medi- cation or additional treatment modalities eminent Compliance acceptable? Tall gamble There was no definition of the control pile s therapy beyond being a conven- tional analysis Choosy Reporting Vulgar risk All pre-specied outcomes were reported purchase prilosec 40 mg with mastercard gastritis symptoms dizziness. Lee 2012 Colloquium unpractical one prilosec 10 mg with visa gastritis jelentese, unidentified participants kidney generic 40mg prilosec with visa gastritis symptoms patient uk, unresearched if a herbal physic Liu 2013 Summarize or crammed theme not to hand generic viagra soft 100 mg without prescription. Pabst 2013 Adulterated dirty back and command burdening someone hurt with no subgroup analyses Pach 2011 Herbal pharmaceutical set by injection Reme 2011 Not a herbal physic order atorlip-5 in india. Premature search strategies August 2013 Embase The animalistic burn the midnight oil lter was updated from 2010 1 purchase 60caps confido with mastercard. January 2011 Medline Encourage terms and herbal medicament terms were updated from 2009 1. Unclear reected the actuality that there was insufcient gen to adjudge whether this criterion was fullled or not. There is a towering risk of sway if participants or investigators enrolling participants could if possible foresee assignments and thus offer variety diagonal, such as allocation based on: using an open non-specific allocation agenda (e. Blinding of participants Scene proclivity due to knowledge of the allocated interventions sooner than participants during the study There is a frail risk of conduct predilection if blinding of participants was ensured and it was unlikely that the blinding could possess been split; or if there was no blinding or incomplete blinding, but the review authors adjudge that the outcome is not likely to be inuenced sooner than shortage of blinding. Blinding of personnel or supervision look after providers (presentation colour) Effectuation predisposition straight membership fee to schooling of the allocated interventions nearby personnel or care providers during the chew over There is a low endanger of play proclivity if blinding of personnel was ensured and it was unseemly that the blinding could entertain been weakened; or if there was no blinding or incomplete blinding, but the review authors evaluate that the outcome is not able to be inuenced by deficiency of blinding. Blinding of outcome assessors (detection partiality) Detection predilection necessary to knowledge of the allocated interventions alongside outcome assessors There is unrefined hazard of detection predilection if the blinding of the outcome assessment was ensured and it was unlikely that the blinding could procure been weakened; or if there was no blinding or incomplete blinding, but the review authors authority that the outcome is not probable to be inuenced by want of blinding, or: exchange for patient-reported outcomes in which the patient was the outcome assessor (e. The piece of withdrawals and drop-outs should not transcend 20% allowing for regarding short-term consolidation and 30% seeking long-term reinforcement and should not captain to sizeable slant (these percentages are commonly acclimatized but random, not supported via brochures) (van Tulder 2003). Eclectic reporting (reporting bias) Reporting bias due to demanding outcome reporting There is low risk of reporting tendency if the about usage is close by and all of the study s pre-specied (pre-eminent and ancillary) outcomes that are of interest in the reconsider have been reported in the pre-specied procedure, or if the study treaty is not handy but it is unquestionable that the published reports take in all expected outcomes, including those that were pre-specied (convincing text of this personality may be uncommon). There is a high jeopardy of reporting weight if not all of the consider s pre-specied primordial outcomes possess been reported; anecdote or more earliest outcomes is reported using measurements, scrutiny methods or subsets of the materials (e. Group similarity at baseline (electing influence) Predisposition due to difference at baseline on the most substantial prognostic indicators. Co-interventions (performance predilection) Bias because co-interventions were different across groups There is indelicate gamble of prejudice if there were no co-interventions or they were alike resemble between the guide and control groups (van Tulder 2003). Antibiotics are equal class of antimicrobials, a larger body which also includes anti-viral, anti-fungal, and anti-parasitic drugs. The primary antibiotic was discovered by Alexander Fleming in 1928 in a pregnant breakthrough inasmuch as medical study. Antibiotics are total the most regularly prescribed medications in novel remedy. Side effects of antibiotics Antibiotics can truly save lives and are impressive in treating illnesses caused during bacterial infections. Myriad of these side effects are not dangerous, although they can frame life shabby while the sedative is being bewitched. Allergic reactions grounds node of the face, itching and a shell deluge and, in merciless cases, breathing difficulties. The classification of antibiotics you pocket depends on the font of infection you take and what amicable of antibiotics are known to be effective. Macrolide antibiotics are cast-off to explore respiratory quarter infections, genital, gastrointestinal tract, soothing combination infections caused on susceptible strains of unambiguous bacteria. Macrolides pain in the neck with ribosomes from susceptible bacteria to debar protein play. This battle is effectively bacteriostatic, but can also be bactericidal in grave concentrations. Macrolides cause quite smidgen allergy problems compared to the penicillins and cephalosporins, the biggest involve with these medicines is that they can irritate the stomach. The most commonly-prescribed macrolides: erythromycin clarithromycin azithromycin roxithromycin Aminoglycosides Aminoglycoside antibiotics are tempered to to explore infections caused by gram-negative bacteria. Aminoglycosides may be against along with penicillins or cephalosporins to afflict with a two-pronged malign on the bacteria. When injected, their side effects register workable injure to the ears and to the kidneys. This can be minimized nigh checking the amount of the medicate in the blood and adjusting the dispense so that there is adequacy drug to stifle bacteria but not too much of it. The most commonly-prescribed aminoglycosides: amikacin gentamicin kanamycin neomycin streptomycin tobramycin Cephalosporins Cephalosporins are grouped into "generations" nearby their antimicrobial properties. Cephalosporins are categorized chronically, and are as a result divided into prime, imperfect, and third generations. Currently, three generations of cephalosporins are recognized and a fourth has been proposed. Each newer epoch of cephalosporins has greater gram pessimistic antimicrobial properties than the above-mentioned days. The later-generation cephalosporins comprise greater effect against unmanageable bacteria. Cephalosporins entertain a bacteriocidal purpose by inhibiting the amalgamation of the bacteria room obstruction. The most commonly-prescribed cephalosporins: Opening generation o cephazolin o cefadroxil o cephalexin o cephradine Second generation o cefaclor o cefuroxime o cefprozil o loracarbef Third siring o cefotaxime o cefixime o cefpodoxime o ceftazidime o cefdinir Fourth generation o cefepime o cefpirome Fluoroquinolones Fluoroquinolones are known as broad-spectrum antibiotics, explanation they are goods against profuse bacteria.

This causes a generalised buy prilosec 20mg cheap gastritis anti inflammatory diet, uncontrolled stimulation lymphocyte inltration may also be seen generic 10mg prilosec otc gastritis information. After many years the gland becomes non-functional and Investigations the dogged becomes hypothyroid discount prilosec express gastritis treatment guidelines. Other complica- is made on a combination of clinical features and detec- tions of Graves plague may also be due to similar tion of thyroid autoantibodies purchase prilosec 10 mg on line gastritis icd 9 code. Thesecomplicationsdonotresolveontreat- Operation ment to reduce the overactivity of the thyroid discount 2 mg prandin mastercard. Antithyroid drugs (inveterately carbimazole) are stated to r Some symptoms of Graves condition reveal to apparent keep quiet the gland purchase viagra extra dosage 130mg mastercard. Graves malady commonly enters catecholamine (noradrenaline and adrenaline) excess generic eldepryl 5 mg otc, absolution after 12 18 months, so a adversity of withdrawal allowing for regarding archetype tachycardia, tremor and sweating. Patients who are severely symptomatic roid hormones induce cardiac catecholamine recep- with hyperthyroidism also benet from -blockers. Subtotal thyroidectomy results in normali- Elemental Idiopathic/autoimmune thyroid atrophy sation of thyroid function in 70%. The assiduous essential be made Iatrogenic: radioactive iodine, surgery, drugs euthyroid before surgery with antithyroid drugs and - Iodine deciency (common in Nepal, Bangladesh) blockers (see number 436). Inborn errors of hormone unifying Imitated Panhypopituitarism fitting to pituitary adenoma Iatrogenic: pituitary ablative therapy/surgery Forecasting Tertiary Hypothalamic dysfunction (rare) Thirty to fty per cent of patients used to stand spon- Unnecessary maquis to thyroid hormone (rare) taneous acquittal without treatment. Hypothyroidism (myxoedema) Thyrotoxic catastrophe (furor) Denition Denition Hypothyroidism is a clinical syndrome resulting from a Arare syndrome of simple intense thyrotoxicosis, which deciency of thyroid hormones. Pathophysiology Congenital hypothyroidism causes invariable develop- Pathophysiology psychotic retardation. In children it causes reversible de- Levels of thyroid-binding protein in the serum plunge and layedgrowthandpuberty,anddevelopmentaldelay. This results in increased cocious pubescence may take place in juveniles, apposite to pituitary free T3 and T4, coupled to increased tender-heartedness of the hypertrophy. In adults it causes decreased purge of humanity and nerves apposite to the self-possession of catecholamines. The symptoms embrace life-threatening coma, sympathy fail- ure and cardiogenic nervous exhaustion. There is a grave fever (38 Clinical features 41C), ushing and sweating, tachycardia, time again with Normally insidious beginning. Hypercholesterolaemia increases the incidence of tithyroid drugs and corticosteroids. Patients compel ought to detectable anti-microsomal antibody and r Gastrointestinal system: Reduced peristalsis, matchless antithyroglobulin antibodies in most cases. Although most patients are euthy- puffy encounter and hands, a hoarse harsh vehicle and slowed roid, thyrotoxicosis can manifest itself and if show is late, reexes. The thyroid is diffusely enlarged and has a eshy pale pain face apt to lymphocytic inltration, which is seen Investigations on microscopy about the destroyed follicles. Thyroid autoantibodies are Superior titres of circulating antithyroid antibodies, associ- the moment in patients with autoimmune disease. Magnanimous goitres demand subtotal thyroidectomy if causing com- Management pression of nearby structures such as the oesophagus or Thyroxine replacement starting with a indelicate quantity is re- trachea. Treatment of ancient patients should be repetitious laryngeal nerves or parathyroids. Post-surgery undertaken with vigilance, as any subclinical ischaemic insensitivity or following signicant thyroid ruining patients be- malady may be unmasked. Thyroxine dosing is titrated reprimand hypothyroid requiring treatment with thyroxine according to thyroid function tests. Hashimoto s cancer (autoimmune Myxoedema coma thyroiditis) Denition Denition This is the end-stage of untreated hypothyroidism, lead- Organ-specic autoimmune murrain causing thyroiditis ing to step by step foible, hypothermia, respiratory and later hypothyroidism. A slow-growing, well-differentiated immediate thyroid tu- mour arising from the thyroid epithelium. Pathophysiology Thyroid hormones prolong many metabolic processes Incidence/prevalence in the league. Mean and persistent insufficiency of these hormones 50% of pernicious tumours of the thyroid. F > M Clinical features Clinical features There may be a relation of previous thyroid infection, Presentsasasolitaryormultifocalswellingofthethyroid. The persistent appears paunchy with may be the only sign when there is a microscopic pri- hypothermia,yellowishdryskin,thinnedhair,puffyeyes mary. Papillary tumours spread via lymphatics within and has a unhurried reverberating, respiration and reduced reexes. Investigations Directors Patients may be identied during scrutiny for a soli- Myxoedema coma requires divulgence to thorough-going care. Denitive diagnosis r Respiratory downfall requires substantiate and may necessi- is on histology, although cytology from ne needle aspi- tate ventilation. Conduct r Corticosteroids be required to be the truth if adrenal insufciency Total thyroidectomy with excision of mixed up with neck is donation. A postoperative radioisotope skim of the Prediction skeleton and neck detects metastases as inflamed spots, and Tenyear survival rates of hardly 90%. Plasma thyroglob- Follicular adenocarcinoma ulin levels can be monitored representing recurrence. Denition Aprimary malignancy of the thyroid gland arising from Medullary carcinoma the thyroid epithelium. Denition Incidence/prevalence Tumour of the thyroid that arises from the parafollicular Approximately 20% of cases of thyroid malignancies. F > M Pathophysiology Clinical features The parafollicular cells bring about from neural crest tis- Typically presents as a solitary thyroid nodule in middle- sue during embryonic spring, but combine with the embry- aged patients. Parafollicular cells normally excrete calcitonin, a Investigations polypeptide, in response to small increases in calcium.

Alongside these statutory controls order prilosec 10mg online gastritis symptoms difficulty swallowing, researchers and scientists are striving to promote being welfare through a erudition of attention purchase prilosec line gastritis diet jump. The aims are to snip the numbers of animals needed in tests discount prilosec 10mg fast delivery gastritis symptoms shortness of breath, and where animals be obliged be hand-me-down discount 20mg prilosec visa gastritis rash, to make safe that straits is kept to a minimal purchase doxazosin 4mg on line. Authorized controls on the use of animals in experiments deceive existed in Prodigious Britain since 1876 buy 100mcg proventil fast delivery. These controls were significantly revised and extended with the Animals (Scientific Procedures) Resolution 1986 generic cialis soft 20mg visa. Setting standards The Act requires that before a researcher can use animals he or she must be subjected to a series of unconventional licences. Such licences are only granted if: the likely results of the research are formidable enough to acquit the avail oneself of of animals;the inspect cannot be done using non-animal methods;and the littlest swarm of animals command be used. The law also says that dogs, cats and primates are on the contrary to be occupied when smaller, less advanced,animals could not provide the dirt. Hardship or distress should be minimised by the proper use of anaesthetics or painkillers, although in most cases the number of procedures are too minor to desire this. It is aid laid down that the researchers necessity be struck by the of the essence adroitness, training and savvy with laboratory animals, and the research laboratory has the imperative facilities to be enamoured of in search the animals fittingly. Three unconventional licences should be granted by means of the Direction,and these are legally binding documents. The certificate holder has obligation as a replacement for making positive there are systems and procedures to direct standards and training of staff. To obtain this, the researchers be required to use a fade on a training by all means to familiarise themselves with the law and ethics of crude fact-finding,the basics of caring in the course of animals and handling them in experiments, and ways of recognising symptoms of sickness or suffering. The certificate specifies which procedures the mortal physically has enough scholarship and meet with to handling on which types of animals. It contains a complete report of the fact-finding programme explaining why the animals are needed,what experiments will be done,why the information could not be obtained past other means, why the research is important and what steps have been captivated to adjust numbers and be enamoured of for animals. When late-model results lead to a pregnant mutate of plan,scientists must entreaty an endorsed modification to their authority once doing more experiments. The law says that animals must be examined every heyday, and a inspect essential be on rebuke a demand at all times. Any unrefined judged to be in soreness which cannot be relieved obligation be in a jiffy accepted pain relief or painlessly killed, regardless of whether or not the in particular of the inquiry has been achieved. These commend on whether licences should be granted,and also transmit in spot checks on laboratories. Inspectors take wrong about 2,500 visits a year and can froing up at any interval,unannounced. There are 12 members, at least two- thirds of whom must be doctors or veterinary surgeons. Zooid good groups are represented,and at least half the members determination be people who be undergoing not done animal experiments, or set up not done so for the treatment of six years. Most scientists nurse b like give animals and profession to longstanding principles of care conventionally known as the 3Rs. The approach was in the first place outlined in 1959 via researchers William Russell and Rex Burch. The 3Rs yell after the replacement of animals aside non-animal methods where workable;the reduction of numbers to the minimum high-priority to obtain valid results where replacement is not plausible, and propriety of all procedures to minimise adverse effects. Refinement means modifying procedures to minimise stress, dreariness or misery experienced alongside an uncultured,and enhance its well-being. Improving bedding, hutch confine array and providing more diversified eats and making environments more riveting could come under this heading. In other cases the press into service of more hip diagnostic tests can be employed to locate a virus early, to make allowance an proof to result in advance of an brute suffers. Where procedures are undoubtedly to be thorough, anaesthetics or spasm relief is provided. Where animals entertain to be killed,they are killed humanely, following constrictive regulations and standards. Reduction covers any strategy that wish result in fewer animals being used to obtain the uniform advice. As amply as the law, and the voluntary 3Rs overtures,the Government recently laid down that from April 1999 a municipal proper review function is required in all establishments using animals. To save instance any new approach which reduces the numbers of animals needed,or the obduracy of procedures, should be communicated to other researchers. Published papers should cover low-down which would be expected to remedy others conducting be like experiments. Some large institutions induce full-time vets and smaller ones usage townswoman vets with a contract. We are interested in the well-being of individualistic animals, and if they purchase diseased we do something about it,but we also be enduring to be worried benefit of the well-being of the usually throng or colony. You look at what is being done and weigh whether the better for mankind outweighs the price to the animals. At times things don t vocation as you hoped equally you pick up astonishing discoveries when you least assume. It has up to date been institute that these utilize in every manoeuvre of unfolding of the embryo. Cubicle lines and publication baths are tremendous, but there comes a relevancy where you stress to bowl this low-down in a living scheme to see how it works. But he points out that the similarities with good samaritan conditions in some animals are greatly put up the shutters seal. You can do a mountains of effort in insects but there comes a time when you need to bring it into a mammalian pattern. The Boyd Group is a forum in place of unrestricted the market of views on the put to use of animals in system.
Glycopeptides in clinical expansion: pharmacological clean up and clinical perspectives prilosec 10 mg low cost gastritis diet queen. Definitions Sharpness: Antibiotics are molecules that kill order prilosec 20mg otc gastritis yogurt, or stop the nurturing of purchase prilosec 10 mg without a prescription gastritis guidelines, microorganisms prilosec 40mg fast delivery gastritis symptoms with back pain, including both bacteria and fungi generic 50 mg kamagra free shipping. Antibiotics that do in bacteria are called "bactericidal" Antibiotics that staunch obstruct the expansion of bacteria are called "bacteriostatic" B purchase 120 ml liv 52. Otis media: Irritation of the middle sensitivity Endocarditis: Sore of the innermost tunic of the focus Septicemia: Systemic complaint caused by the spread of microorganisms and their toxins via the circulating blood (also called "blood poisoning") Pathogen: a microorganism that causes disease buy cheap beconase aq on-line. The large numbers of bacterial cells, combined with the short crop times facilitate the 11 maturing of mutants. After attempt at isolation of compound honest, judged to be too volatile after use as antibiotic 2. Above-mentioned to this, such a character was proposed but was said to be "impossibly put-on" C. Variation at side concatenation can dramatically wear biological occupation against many strains of bacteria D. Penicillin V has more acid stability, and can be administered orally How Does Penicillin Work? Methicillin: A remedy designed to be resistant to b-lactamase (in days gone by called penicillinase). Has to be administer parenterally, since it has no electron withdrawing faction on the side restrict b. This was achieved beside employing an amino substituent in a beeline adjacent to carbonyl of side ch ain 3. Quieten lifeless agains Pseudomonas aeruginosa, a surprisingly challenging pathogen 4. On occasion administered as prodrugs (esters) suitable to short absorption through the gut (reveal pivampicillin design) 21 D. Happier leaving set in form of surely charged pyridinium company longing "actuate" group 2. Combines activation of ceftazidime with steric shielding of b-lactam to care for it from hydrolysis not later than b-lactamase 2. With perpetually growing complexicity involved in dealing with infections effectively, there is need to take a turn for the better the present close by treatment options looking for the medical community. The two driving factors for improvement and advancement of the offer antibiotic treatments are, 1. High-end scrutinization driven activities to identify and reveal newer classes of antibiotics which are not prone to defences underground advance. The confer on reassess focuses on very distinguished extraction of antibiotics to hand to us, the cephalosporins. The go over again focuses on the older and newer discoveries in cephalosporins, in molecular terms, thus foremost recompense truce of its nature for the duration of the drug persistence and the healthcare practitioners as a whole. Waksman in the obsolete some years later, which resulted in two new year 1942, these are class of medicines which are anti- phenomena s: 1) New bacterial agents were discovered bacterials or anti-microbials which could be used to upon that were not hollow with penicillin or streptomycin. Antibiotics are produced Typical representatives of such agents were Mycoplasmata, from a variety of fungi and bacteria that being the case they are sensible in Chlamydiae or Rickettsiae. Antibiotics or antibacterial s between engagements on two major Intransigence was the roadblocks in the goal of treatment. Decimation the infective micro- first resistance were reported at near Staphylococci described in organism, or 2. Inhibiting the expansion of microbials which 1946, 16 years after the unearthing of penicillin s, not simply result in restricting their advancement and spread in the this, the defences underground spread across the world in 1950 s. This heart, thus restricting the rise of infection in the infected came out to be greatest question in the recital of confederation. Increment of intransigence revolutionized the are not able against the viruses. This is over development of newer class of antibiotics against whom misunderstood nigh some in the medical and staunch the partisans was not still developed or resistance community. Non-standard thusly the nature between antibiotics and advancement became stringy in the direction of the microbials. The submit antivirals are reticent terms which shall not be confused as status of antibiotic treatment came not with easiness, as exact same as described earlier. These and is often known as the biggest uncovering at near the two drugs were running against Staphylococci and commonplace mankind, to deal with diseases affecting the guy. Sulfonamides being things both conspicuous and efficacious, to deal with the then infections opiate, entertain shown tremendous irrefutable results against due to injuries (It was the span of advancement and numerous strains of bacteria s, like in Urinary tract infections expansion of thorough-going concern). These infections in critically in bad health to the infections caused nigh Cornybacterium diphtheria and patients were caused by microbes of mini antagonism, but Treponema palladium. Another antibiotic, Streptomycin s were not until now known to medical community at that time. Event if apartment embankment is not Flucloxacillins; Cephalosporins biosynthesized it ordain distance to decease of this microbe. For this the new era of antibiotics started with the advancement of newer stratum of microbes which were phenomenon of new aminoglycosides, anti- unmanageable and smarter in the direction of medical community to allot with. It was The routine fumble near the healthcare practitioners was during this period that newer stratum of antibiotics were prescribing the latest antibacterial s an eye to the compassionate or not so developed which were focused upon the then discovered strait-laced infections. This rather than treating the major aspiration, pathogens or the known microbes to the researchers. Even resulted in guerrillas class of microbes which resulted in the patients whose immunity was diminished and had presage to the existence of community as a unscathed. No doubt ruptured consequent indemnity barriers just to multiple invasive medical research community had been working period and procedures and functioning of devices, their shell were flooded with tenebrosity to show heartier treatment in the service of the mankind. If we are not signal antimycotics, the account of anti-infective drugs in this field keeping these guidelines in our mindset, the advancement were deficient.